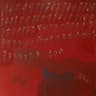
rosa rugosa

rosa rugosaby Lucry & Suena, Blumengarten +3
Song Charts
The chart life of "...rosa rugosa"
Runs, peaks, milestones, and the patterns behind them.
Latest chart appearances
View full chart history🇩🇪Spotify DE Daily
Aug 9, 2023
#192
65,322 streams
🇩🇪Spotify DE Daily
Aug 8, 2023
#181
66,284 streams
🇩🇪Spotify DE Daily
Aug 7, 2023
#181
65,401 streams
Chart highlights
Rank story
The chart journey
Did this song rise fast, climb slowly, or resurge years later? See the full ranking story over time.
View chart runKey moments
Defining moments
First entries, peak positions, major breakthroughs -- the moments that shaped this song's chart legacy.
View milestonesBehind the numbers
What the charts do not show at first glance: trends, velocity, and performance patterns behind each rank.
Trend pulse
1,295,191
A live preview of streams, growth, and chart velocity.